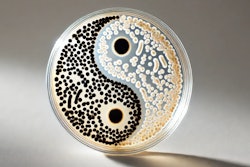

AFB International, a global leader in pet food palatability solutions, has opened its new Asia Pacific Regional Headquarters and state-of-the-art manufacturing facility in Samut Prakan, Thailand.
The company said the facility will play a key role supporting the rapid growth of the pet food industry in Asia while enabling AFB to better meet the evolving needs of its customers in the region. With this facility in Asia, AFB said it will be able to enhance operational efficiency and ensure a more reliable supply chain, allowing for faster delivery and improved service.
“The opening our facility in Thailand marks a major milestone in our global expansion efforts," said Dale Spence, president of AFB International. "Our customers asked us to be local, and now we are. This facility strengthens our commitment to the region, allowing us to better serve our customers with enhanced efficiency, speed, and local support."
The new facility will serve as the regional hub for AFB International’s Asia Pacific operations, bringing together corporate offices, manufacturing, R&D, and quality teams under one roof.
“Thailand, the world’s third largest pet food exporter, is an ideal location for our new facility,” said Bas Melssen, general manager/vice president of Asia Pacific. “As a hub for innovation in the pet food industry, Thailand aligns perfectly with our commitment to advancing product development and manufacturing excellence. Establishing our Asia Pacific headquarters here allows us to leverage Thailand’s expertise and leadership in the sector, being closer to our existing customers here, while further enhancing our ability to innovate and meet the growing demands of the region.”
Stephanie Hackmann, vice president of global operations, noted the Thailand facility is a crucial step in aligning the company's operational goals with its sustainability objectives. “By localizing production, we can serve our customers more efficiently, respond faster to their needs, and significantly reduce transportation-related emissions – a win for both efficiency and the environment," said Hackmann.
The opening ceremony welcomed over 130 guests from seven countries, including representatives from leading pet food manufacturers and trade associations across Asia.
According to Petfood Industry, AFB International provides palatant solutions that enrich the relationship between pets and their people. The company brings value to pet food manufacturers with its research expertise, technical support and customer service.
Adapted from a press release.